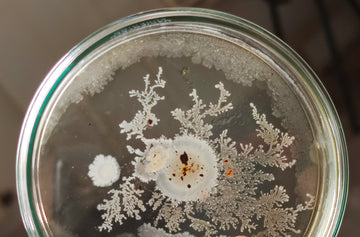

Parallelogram
Explore the science of precision health through the lens of the skin microbiome. Discover expert insights, practical tips, and the latest research in our blog. Join us in unlocking the secrets to radiant, resilient skin!

Precision Phages: The Natural, Safe Solution for Clearer Skin
personalized health , phage therapy , skin longevity , skin microbiome
How to Improve Your Skin Microbiome: The Science Behind Prebiotics, Probiotics, Postbiotics, and Phages
ingredients , skin longevity , skin microbiome
Get Your Teen Ready for the School Year: Why Phage Serums Are a Better Choice Than Accutane
phage therapy , skin microbiome , teens
Thinking about permanent makeup or tattoo? Take precaution.
antimicrobial resistance , skin disease , skin microbiome
How diversity improves health outcomes for all
diversity , skin microbiome
Treating skin diseases by leveraging the skin microbiome
skin disease , skin microbiome